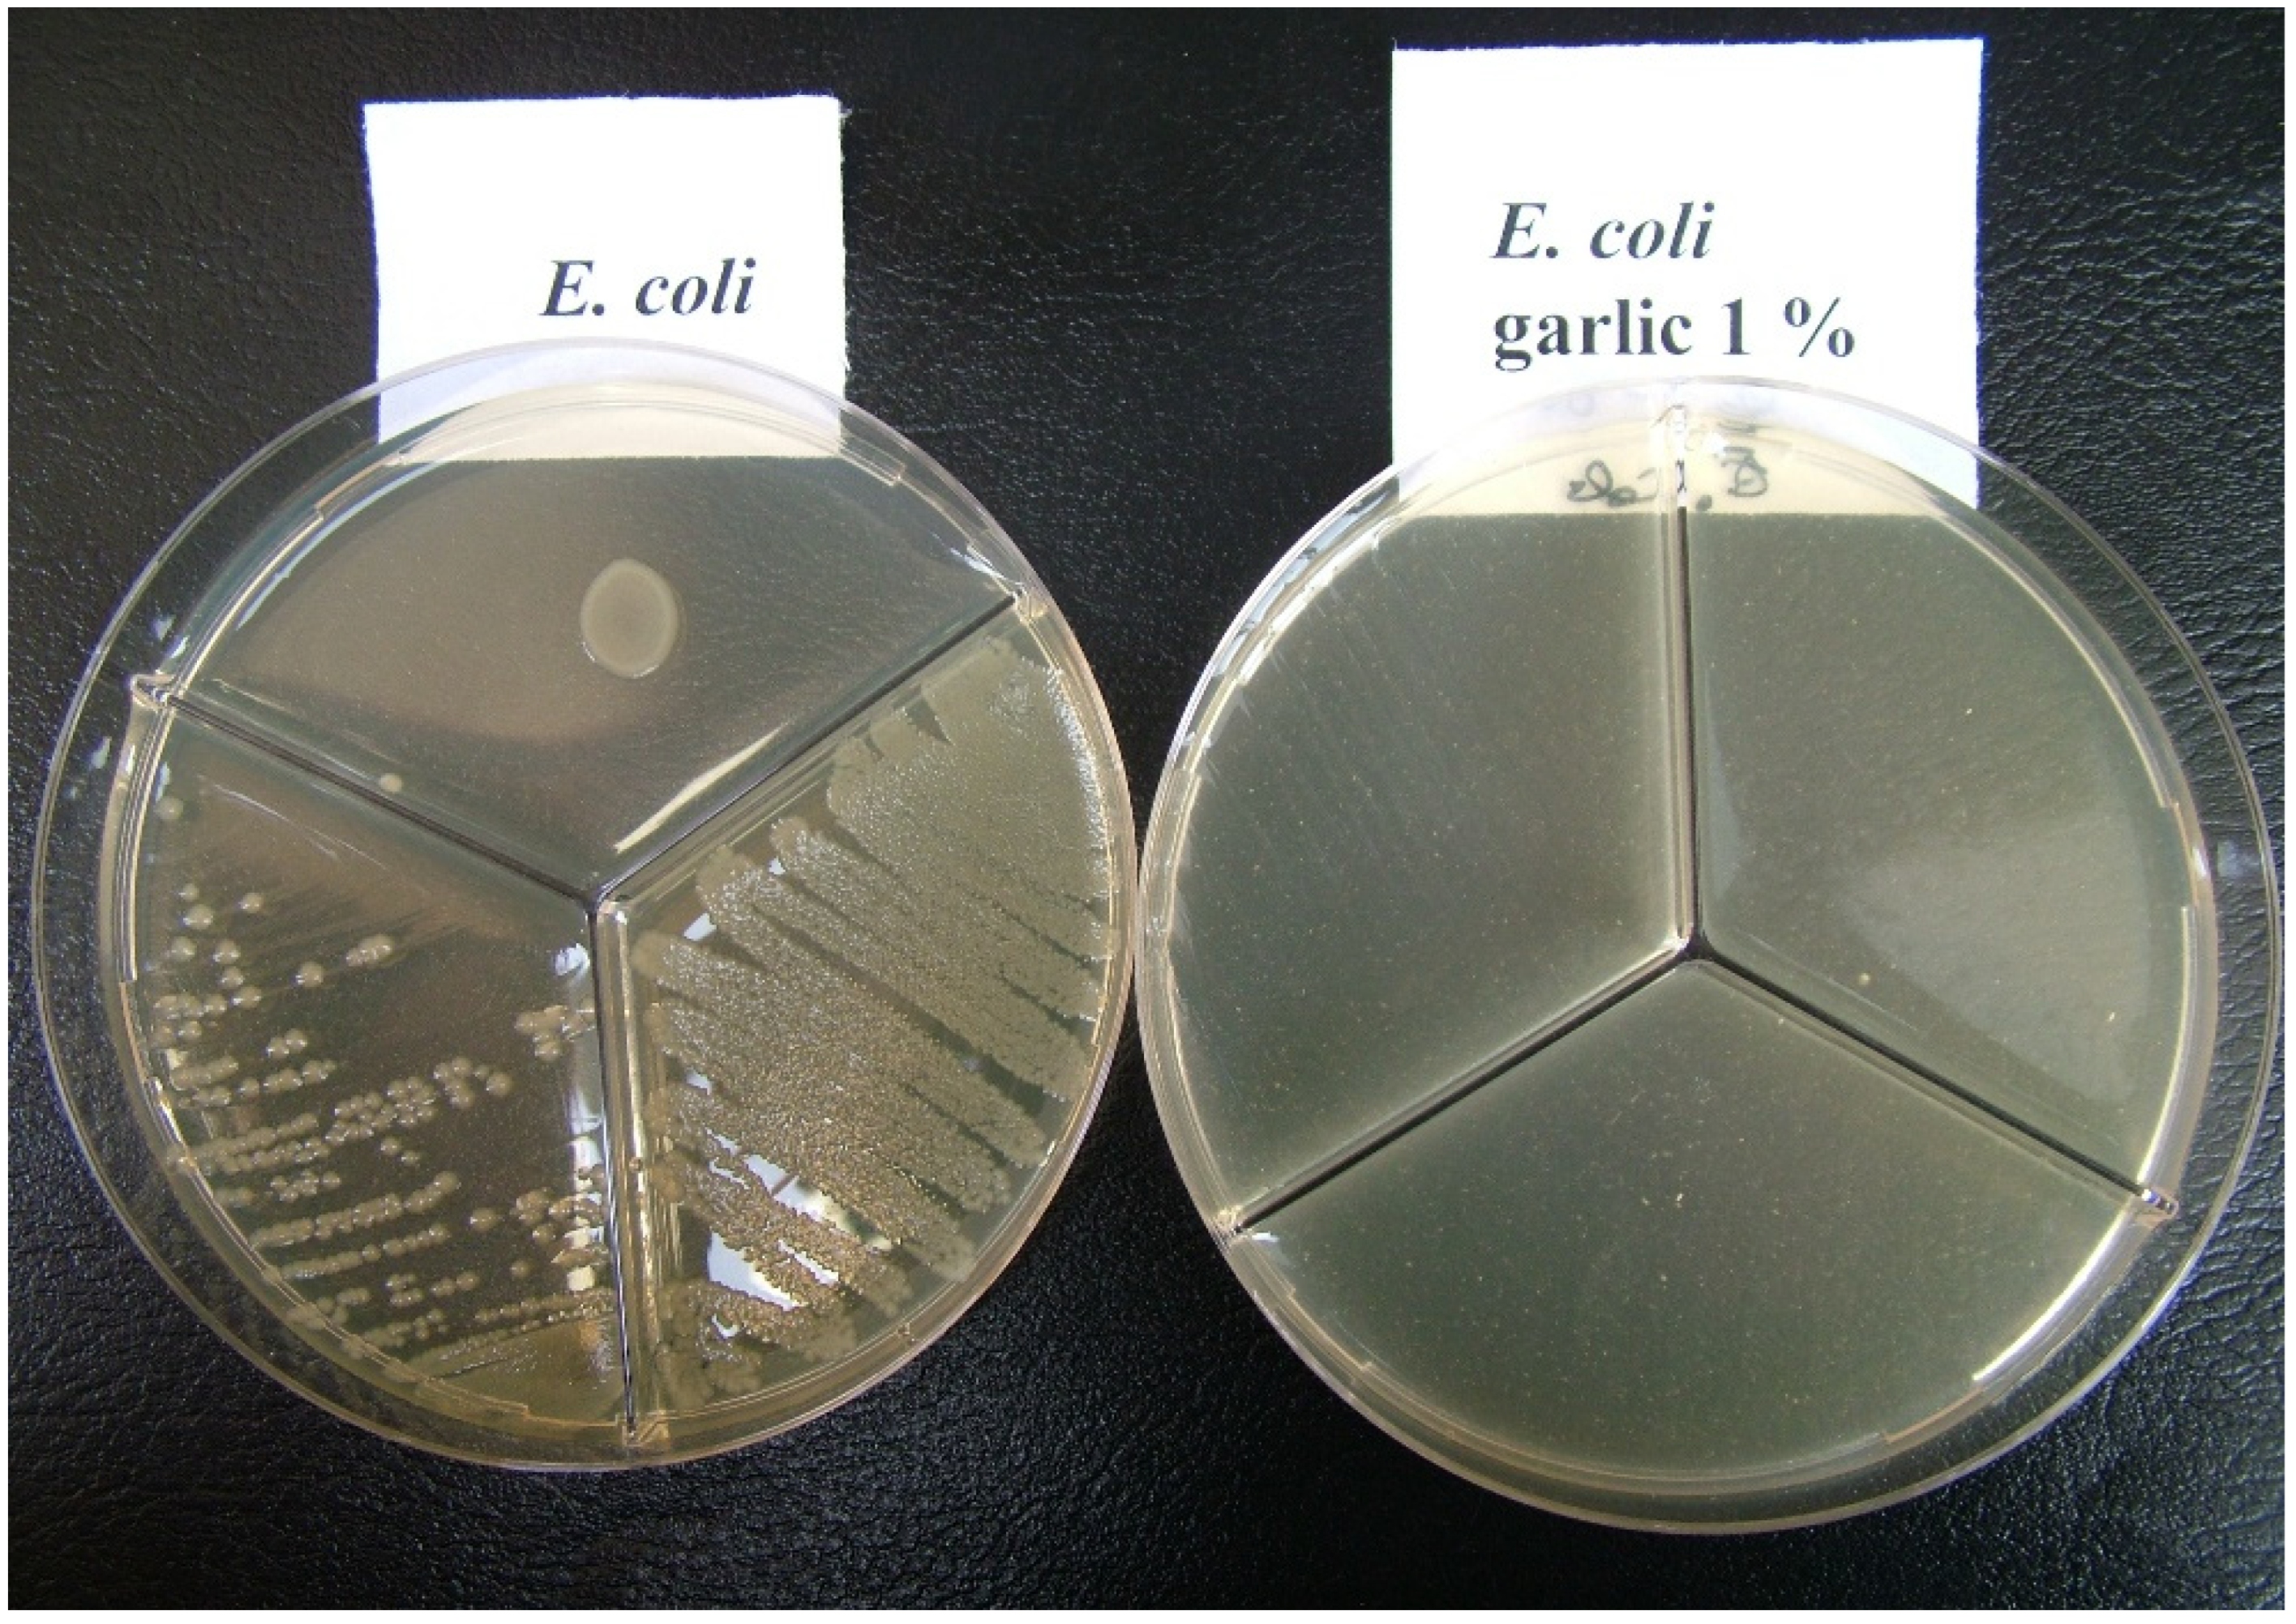
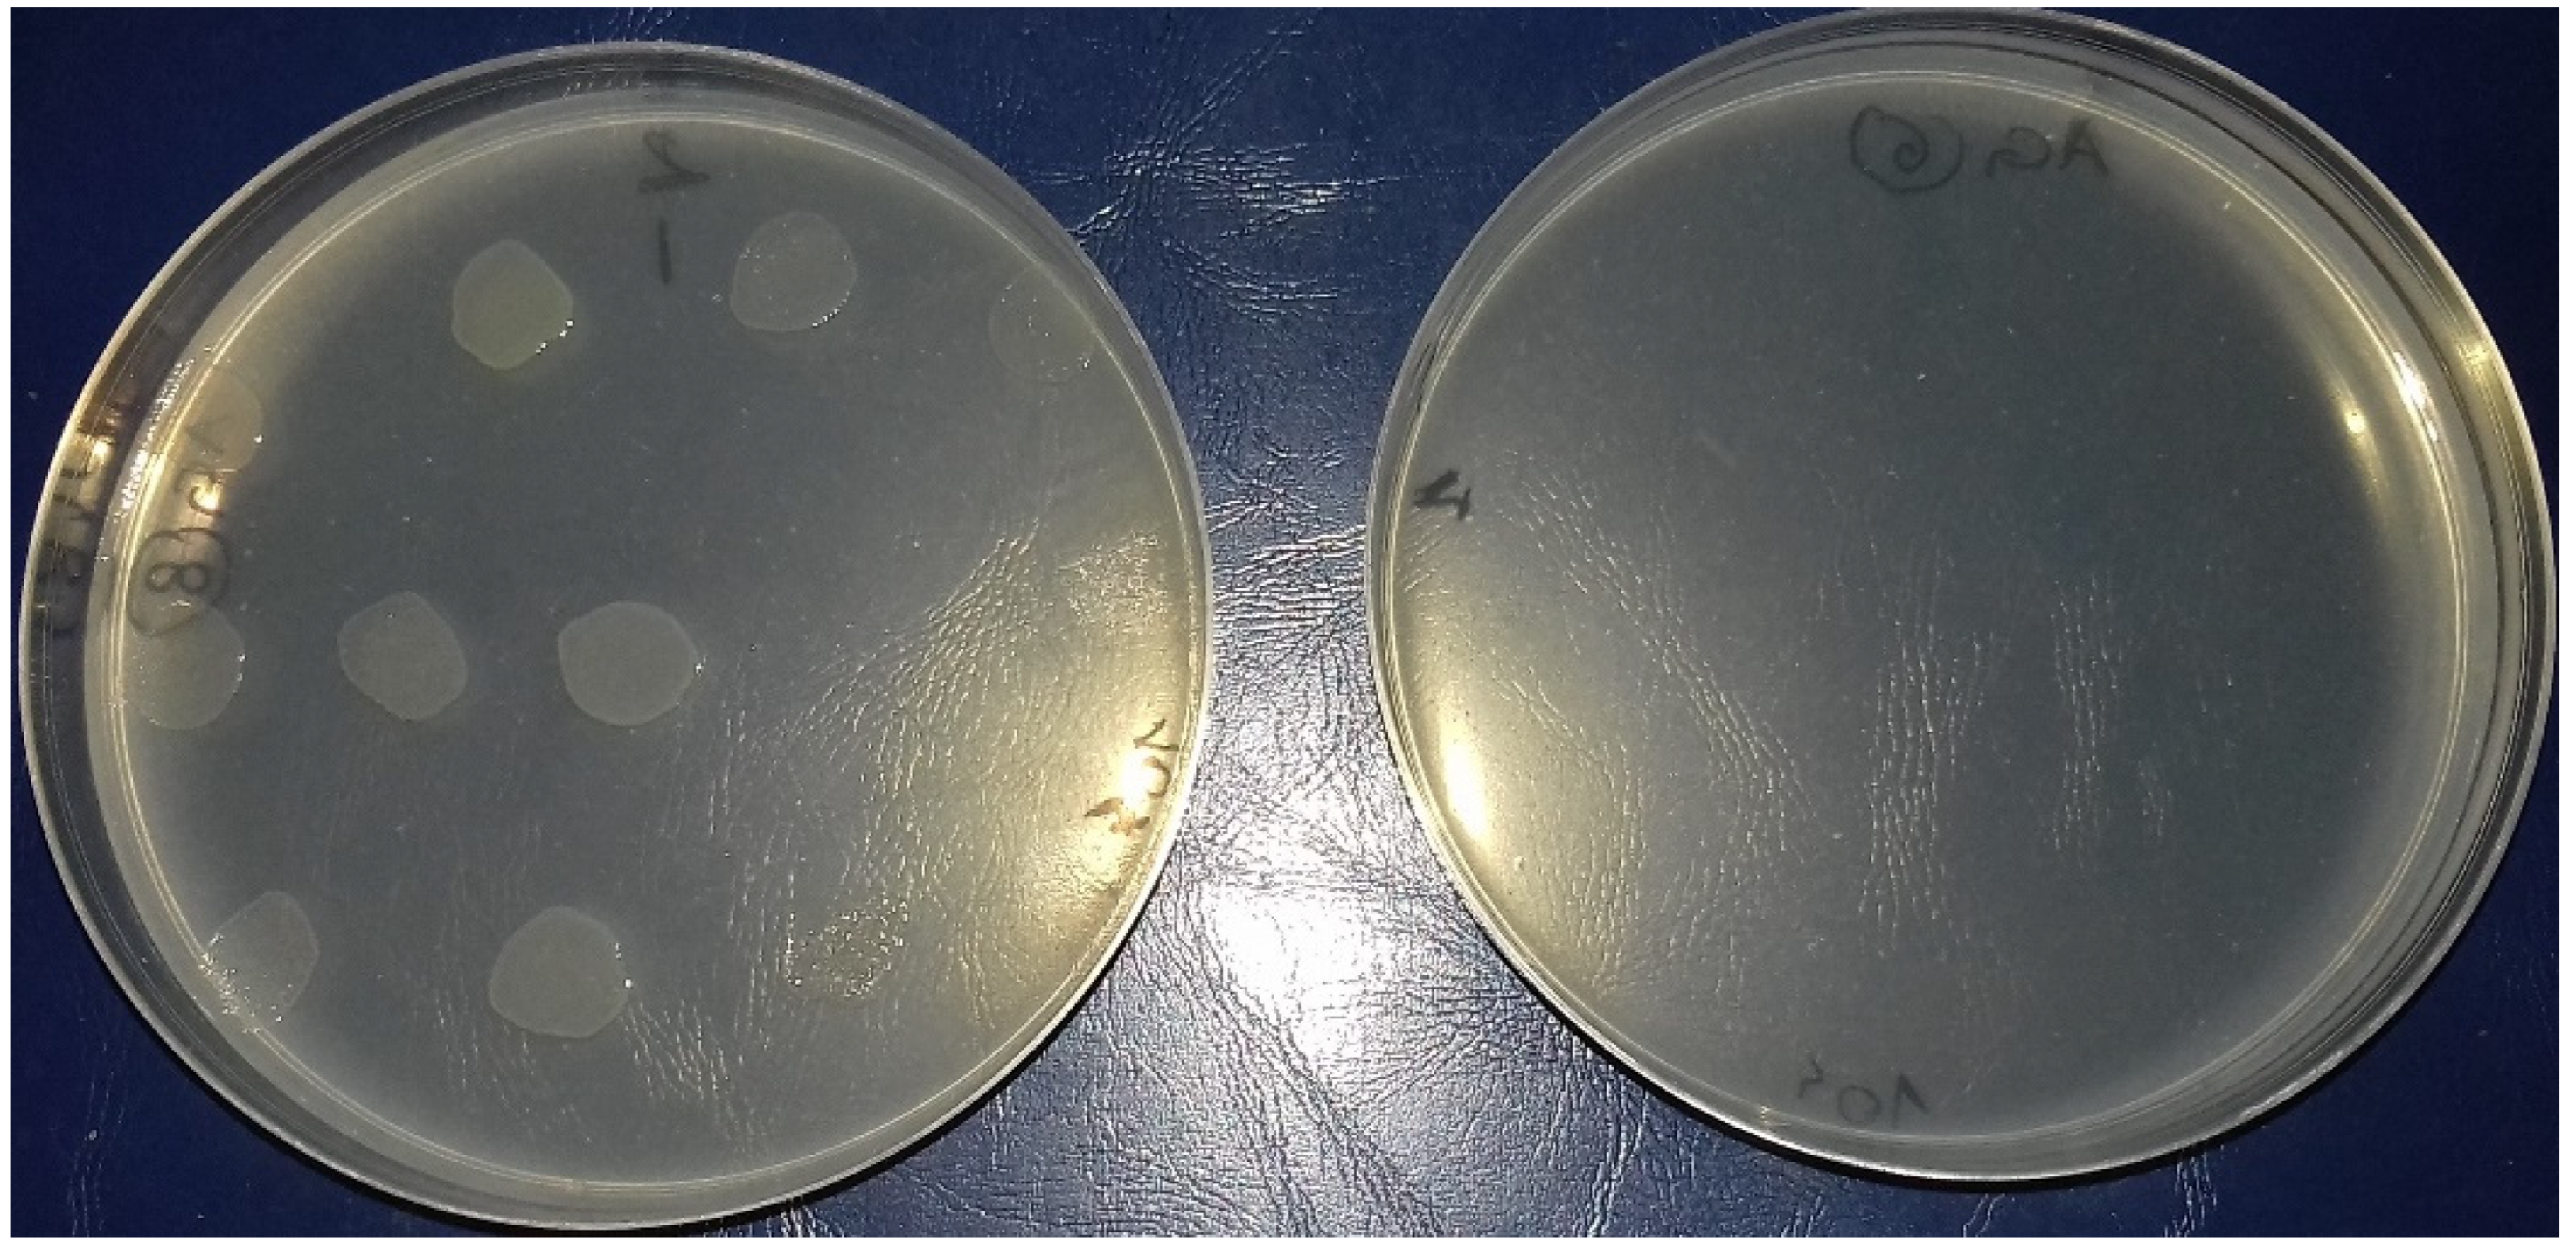
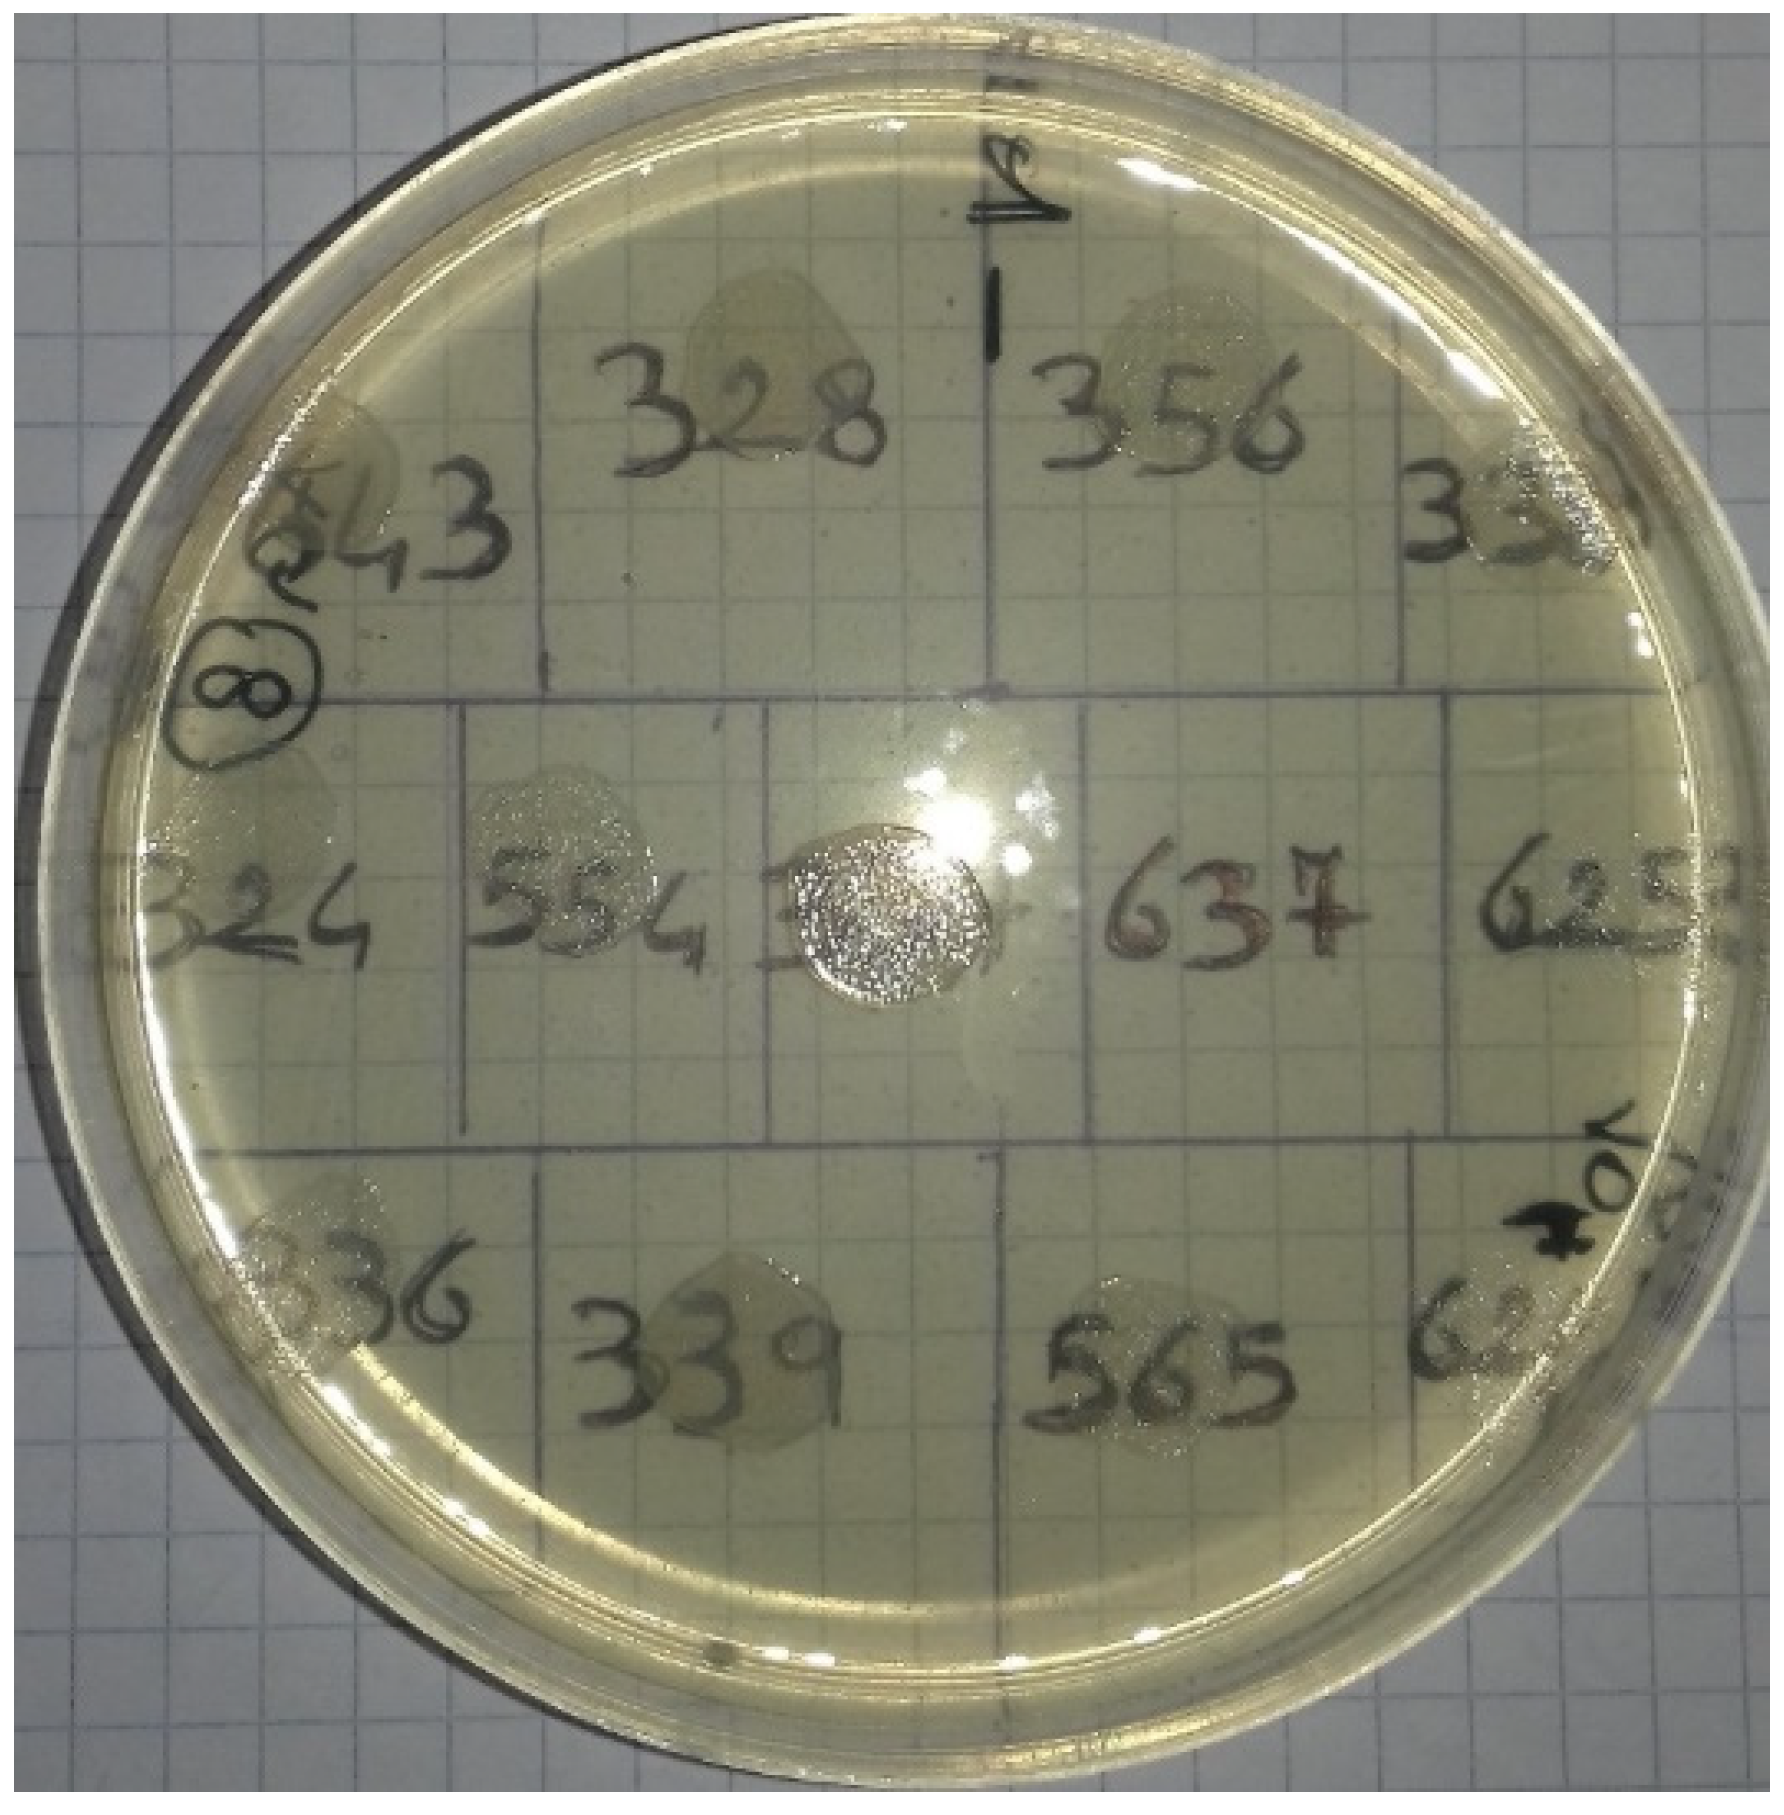

In Vitro Antimicrobial Effectiveness Tests Using Garlic (Allium sativum) against Salmonella enterica Subspecies enterica Serovar Enteritidis
Abstract
1. Introduction
2. Material and Methods
2.1. Strains Used for Bacterial Suspensions
2.2. Preparation of Aqueous Garlic Extract (AGE)
2.3. Preliminary Test
2.4. Preparation of Efficacy Tests
2.5. Statistical Data Evaluation
3. Results
4. Discussion
5. Conclusions
Author Contributions
Funding
Institutional Review Board Statement
Informed Consent Statement
Data Availability Statement
Acknowledgments
Conflicts of Interest
References
- Reygaert, W.C. An overview of the antimicrobial resistance mechanisms of bacteria. AIMS Microbiol. 2018, 4, 482–501. [Google Scholar] [CrossRef] [PubMed]
- Regulation (EU) No 2016/429 of the European Parliament and of the Council of 9 March 2016 on Transmissible Animal Diseases and Amending and Repealing Certain Acts in the Area of Animal health (Animal Health Law). Available online: https://www.legislation.gov.uk/eur/2016/429/introduction (accessed on 30 September 2022).
- Ibrahim, S.A.; Dharmavavaram, S.R.; Seo, C.W.; Shahbazi, G. Antimicrobial activity of Bididobacterium Longum (NCFB2259) as influenced by spices. Internet. J. Food. Saf. 2004, 2, 6–8. [Google Scholar]
- Sharifi-Rad, J.; Dey, A.; Koirala, N.; Shaheen, S.; Omari, N.E.; Salehi, B.; Goloshvili, T.; Silva, N.C.C.; Bouyahya, A.; Vitalini, S.; et al. Cinnamomum Species: Bridging Phytochemistry Knowledge, Pharmacological Properties and Toxicological Safety for Health Benefits. Front. Pharmacol. 2021, 12, 600139. [Google Scholar] [CrossRef] [PubMed]
- Fani, M.M.; Kohanteb, J. Inhibitory activity of Aloe vera gel on some clinically isolated cariogenic and periodontopathic bacteria. J. Oral. Sci. 2012, 54, 15–21. [Google Scholar] [CrossRef] [PubMed]
- Biswas, K.; Chattopadhyay, I.; Banerjee, R.K.; Bandyopadhyay, U. Biological activities and medicinal properties of neem (Azadirachta indica). India Curr. Sci. 2002, 82, 11. [Google Scholar]
- Camarda, A.; Pugliese, N.; Bevilacqua, A.; Circella, E.; Gradoni, L.; George, D.; Sparagano, O.; Giangaspero, A. Efficacy of a novel neem oil formulation (RP03™) to control the poultry red mite Dermanyssus gallinae. Med. Vet. Entomol. 2018, 32, 290–297. [Google Scholar] [CrossRef]
- Tassou, C.C.; Drosinos, E.H.; Nychas, G.J.E. Effects of essential oil from mint (Mentha piperita) on Salmonella enteritidis and Listeria monocytogenes in model food system at 4 degrees and 10 degrees C. J. Appl. Bacteriol. 1995, 78, 593–600. [Google Scholar] [CrossRef]
- Ayaz, E.; Alposy, H.C. Garlic (Allium sativum) and traditional medicine. Turk. Parazitol. Derg. 2007, 31, 145–149. [Google Scholar]
- Badal, D.S.; Dwivedi, A.K.; Kumar, V.; Singh, S.; Prakash, A.; Verma, S.; Kumar, J. Effect of organic manures and inorganic fertilizers on growth, yield and its attributing traits in garlic (Allium sativum L.). J. Pharmacogn. Phytochem. 2019, 8, 587–590. [Google Scholar]
- Capasso, A. Antioxidant action and therapeutic efficacy of Allium sativum L. Molecules 2013, 18, 690–700. [Google Scholar] [CrossRef] [PubMed]
- Nicastro, H.L.; Ross, S.A.; Milner, J.A. Garlic and onions: Their cancer prevention properties. Cancer Prev. Res. 2015, 8, 181–189. [Google Scholar] [CrossRef] [PubMed]
- Lee, D.Y.; Li, H.; Lim, H.J.; Lee, H.J.; Jeon, R.; Ryu, J.H. Anti-inflammatory activity of sulfur-containing compounds from garlic. J. Med. Food 2012, 15, 992–999. [Google Scholar] [CrossRef] [PubMed]
- Percival, S.S. Aged garlic extract modifies human immunity. J. Nutr. 2016, 146, 433S–436S. [Google Scholar] [CrossRef]
- Mehrbod, P.; Amini, E.; Kheir, M.T.; Pasteur Institute of IRAN (Influenza Unit). Antiviral activity of garlic extract on influenza virus. Iran. J. Virol. 2009, 3, 19–23. [Google Scholar] [CrossRef]
- Serrano, H.D.A.; Mariezcurrena-Berasain, M.A.; del Castillo, A.C.G.; Carranza, B.V.; Pliego, A.B.; Rojas, M.T.; Anele, U.Y.; Salem, A.Z.M.; Rivas-Caceres, R.R. Antimicrobial resistance of three common molecularly identified pathogenic bacteria to Allium aqueous extracts. Microb. Pathog. 2020, 142, 104028. [Google Scholar] [CrossRef] [PubMed]
- Castro, C.; Lorenzo, A.G.; González, A.; Cruzado, M. Garlic components inhibit angiotensin II-induced cell-cycle progression and migration: Involvement of cell-cycle inhibitor p27 (Kip1) and mitogen-activated protein kinase. Mol. Nutr. Food Res. 2010, 54, 781–787. [Google Scholar] [CrossRef]
- Batiha, G.E.-S.; Beshbishy, A.G.M.; Wasef, L.; Elewa, Y.H.A.; Al-Sagan, A.A.; El-Hack, M.E.A.; Taha, A.E.; Abd-Elhakim, Y.M.; Devkota, H.P. Chemical Constituents and Pharmacological Activities of Garlic (Allium sativum L.): A Review. Nutrients 2020, 12, 872. [Google Scholar] [CrossRef]
- Zhang, C.; Xie, J.; Li, X.; Luo, J.; Huang, X.; Liu, L.; Peng, X. Alliin alters gut microbiota and gene expression of colonic epithelial tissues. J. Food Biochem. 2019, 43, e12795. [Google Scholar] [CrossRef] [PubMed]
- Arreola, R.; Quintero-Fabian, S.; Lopez-Roa, R.I.; Flores-Gutierrez, E.O.; ReyesGrajeda, J.P.; Carrera-Quintanar, L.; Ortuño-Sahagún, D. Immunomodulation and anti-inflammatory effects of garlic compounds. J. Immunol. Res. 2015, 2015, 401630. [Google Scholar] [CrossRef]
- Mylona, K.; Garcia-Cela, E.; Sulyok, M.; Medina, A.; Magan, N. Influence of two garlic-derived compounds, propyl propane thiosulfonate (PTS) and propyl propane thiosulfinate (PTSO), on growth and mycotoxin production by Fusarium species in vitro and in stored cereals. Toxins 2019, 11, 495. [Google Scholar] [CrossRef]
- Khubber, S.; Hashemifesharaki, R.; Mohammadi, M.; Gharibzahedi, S.M.T. Garlic (Allium sativum L.): A potential unique therapeutic food rich in organosulfur and flavonoid compounds to fight with COVID-19. Nutr. J. 2020, 19, 124. [Google Scholar] [CrossRef]
- Quesada, I.; de Paola, M.; Torres-Palazzolo, C.; Camargo, A.; Ferder, L.; Manucha, W.; Castro, C. Effect of garlic’s active constituents in inflammation, obesity and cardiovascular disease. Curr. Hypertens. Rep. 2020, 22, 6. [Google Scholar] [CrossRef]
- Shang, A.; Cao, S.-Y.; Xu, X.-Y.; Gan, R.-Y.; Tang, G.-Y.; Corke, H.; Mavumengwana, V.; Li, H.-B. Bioactive compounds and biological functions of garlic (Allium sativum L.). Foods 2019, 8, 246. [Google Scholar] [CrossRef]
- Cavallito, C.J.; Bailey, J.H. Allicin, the antibacterial principle of Allium sativum. I. Isolation, physical properties and antibacterial action. J. Am. Chem. Soc. 1944, 66, 1950–1951. [Google Scholar] [CrossRef]
- Choo, S.; Chin, V.K.; Wong, E.H.; Madhavan, P.; Tay, S.T.; Yong, P.V.C.; Chong, P.P. Review: Antimicrobial properties of allicin used alone or in combination with other medications. Folia Microbiol. 2020, 65, 451–465. [Google Scholar] [CrossRef]
- Nakamoto, M.; Kunimura, K.; Suzuki, J.I.; Kodera, Y. Antimicrobial properties of hydrophobic compounds in garlic: Allicin, vinyldithiin, ajoene and diallyl polysulfides. Exp. Ther. Med. 2020, 19, 1550–1553. [Google Scholar] [CrossRef]
- Wilson, E.; Demmig-Adams, B. Antioxidant, anti-inflammatory, and antimicrobial properties of garlic and onions. Nutr. Food Sci. 2007, 37, 178–183. [Google Scholar] [CrossRef]
- Leuschner, R.; Zamparini, J. Effects of spices on growth and survival of Escherichia coli O157 and Salmonella enterica serovar Enteritidis in broth model systems and mayonnaise. Food Control 2002, 13, 399–404. [Google Scholar] [CrossRef]
- Adler, B.B.; Beuchat, L.R. Death of Salmonella, Escherichia coli O157, H7, and Listeria monocytogenesin garlic butter as affected by storage temperature. J. Food Prot. 2002, 65, 1976–1980. [Google Scholar] [CrossRef] [PubMed]
- Gast, R.K.; Jones, D.R.; Guraya, R.; Garcia, J.S.; Karcher, D.M. Research Note: Internal organ colonization by Salmonella Enteritidis in experimentally infected layer pullets reared at different stocking densities in indoor cage-free housing. Poult. Sci. 2022, 101, 102104. [Google Scholar] [CrossRef] [PubMed]
- Mooijman, K.A.; Pielaat, A.; Kuijpers, A.F. Validation of EN ISO 6579-1—Microbiology of the food chain—Horizontal method for the detection, enumeration and serotyping of Salmonella—Part 1 detection of Salmonella spp. Int. J. Food Microbiol. 2018, 288, 3–12. [Google Scholar] [CrossRef] [PubMed]
- CLSI. Methods for Dilution Antimicrobial Susceptibility Tests for Bacteria that Grow Aerobically: Approved Standard, 7th ed.; Clinical Laboratory Standard Institute: Wayene, PA, USA, 2006. [Google Scholar]
- R Core Team. R: A Language and Environment for Statistical Computing; R Foundation for Statistical Computing: Vienna, Austria, 2022; Available online: https://www.R-project.org/ (accessed on 2 September 2022).
- Mohsenipour, Z.; Hassanshahian, M. The effects of Allium sativum Extracts on Biofilm Formation and Activities of Six Pathogenic Bacteria. Jundishapur J. Microbiol. 2015, 8, e18971. [Google Scholar] [CrossRef]
- Jain, I.; Jain, P.; Bisht, D.; Sharma, A.; Srivastava, B.; Gupta, N. Comparative Evaluation of Antibacterial Efficacy of Six Indian Plant Extracts against Streptococcus Mutans. J. Clin. Diagn. Res. 2015, 9, zc50–zc53. [Google Scholar] [CrossRef] [PubMed]
- Andualem, B. Combined antibacterial activity of stingless bee (Apis mellipodae) honey and garlic (Allium sativum) extracts against standard and clinical pathogenic bacteria. Asian Pac. J. Trop. Biomed. 2013, 3, 725–731. [Google Scholar] [CrossRef]
- Gull, I.; Saeed, M.; Shaukat, H.; Aslam, S.; Samra, Z.; Athar, A. Inhibitory effect of allium satibum and Zingiber officinale extracts on clinically Important drug resistant pathogenic bacteria. Ann. Clin. Microbiol. Antimicrob. 2012, 11, 8. [Google Scholar] [CrossRef]
- Yadav, S.; Trivedi, N.A.; Bhatt, J.D. Antimicrobial activity of fresh garlic juice: An in vitro study. Pharmacol. Stud. 2015, 36, 203–206. [Google Scholar] [CrossRef]
- Belguith, H.; Kthiri, F.; Chati, A.; Sofah, A.A.; Hamida, J.B.; Landoulsi, A. Study of the effect of aqueous garlic extract (Allium sativum) one some Salmonella serovars isolates. Emir. J. Food Agric. 2010, 22, 189–206. [Google Scholar] [CrossRef]
- Bhatwalkar, S.B.; Mondal, R.; Krishna, S.B.N.; Adam, J.K.; Govender, P.; Anupam, R. Antibacterial Properties of Organosulfur Compounds of Garlic (Allium sativum). Front. Microbiol. 2021, 12, 613077. [Google Scholar] [CrossRef]
- Bag, A.; Chattopadhyay, R.R. Evaluation of Synergistic Antibacterial and Antioxidant Efficacy of Essential Oils of Spices and Herbs in Combination. PLoS ONE 2015, 10, e0131321. [Google Scholar] [CrossRef]
- Al-Turki, A.I. Antibacterial effect of thyme, peppermint, sage, black pepper, and garlic hydrosols against Bacillus subtilis and Salmonella enteritidis. J. Food Agric. Environ. 2007, 5, 92–94. [Google Scholar]
- Parigi, M.; Massi, P.; Fiorentini, L.; Tosi, G.; Romboli, C.; Vandi, L.; Bocciero, R.; Fregnani, G. Valutazione dell’efficacia di una miscela di acidi organici e fitoterapici nel controllo dell’infezione da Escherichia coli nel tacchino. In Proceedings of the Atti II Simposio Scientfico SIPA, Parma, Italy, 22 September 2017. [Google Scholar]

| Extract Concentration (mg/mL) | N° Inhibited Strains/Analyzed Strains (%) | |
|---|---|---|
| 106 CFU * | 104 CFU * | |
| 10 | 26/26 (100) | 26/26 (100) |
| 9 | 26/26 (100) | 26/26 (100) |
| 8 | 26/26 (100) | 26/26 (100) |
| 7 | 26/26 (100) | 26/26 (100) |
| 6 | 26/26 (100) | 26/26 (100) |
| 5 | 26/26 (100) | 26/26 (100) |
| 4 | 6/26 (23.07) | 24/26 (92.3) |
| 3 | 0/26 (0) | 1/26 (3.84) |
| 2 | 0/26 (0) | 0/26 (0) |
| 1 | 0/26 (0) | 0/26 (0) |
| Extract Concentration (mg/mL) | N° Inhibited Strains/Analyzed Strains (%) | |
|---|---|---|
| 106 CFU * | 104 CFU * | |
| 5 | 26/26 (100) | - |
| 4.75 | 25/26 (96.15) | - |
| 4.5 | 9/26 (34.61) | - |
| 4.25 | 6/26 (23.07) | - |
| 4 | 6/26 (23.07) | 24/26 (92.3) |
| 3.75 | 0/26 (0) | 22/26 (84.61) |
| 3.5 | 0/26 (0) | 11/26 (42.3) |
| 3.25 | - | 1/26 (3.84) |
Publisher’s Note: MDPI stays neutral with regard to jurisdictional claims in published maps and institutional affiliations. |
© 2022 by the authors. Licensee MDPI, Basel, Switzerland. This article is an open access article distributed under the terms and conditions of the Creative Commons Attribution (CC BY) license (https://creativecommons.org/licenses/by/4.0/).
Share and Cite
Circella, E.; Casalino, G.; D’Amico, F.; Pugliese, N.; Dimuccio, M.M.; Camarda, A.; Bozzo, G. In Vitro Antimicrobial Effectiveness Tests Using Garlic (Allium sativum) against Salmonella enterica Subspecies enterica Serovar Enteritidis. Antibiotics 2022, 11, 1481. https://doi.org/10.3390/antibiotics11111481
Circella E, Casalino G, D’Amico F, Pugliese N, Dimuccio MM, Camarda A, Bozzo G. In Vitro Antimicrobial Effectiveness Tests Using Garlic (Allium sativum) against Salmonella enterica Subspecies enterica Serovar Enteritidis. Antibiotics. 2022; 11(11):1481. https://doi.org/10.3390/antibiotics11111481
Chicago/Turabian StyleCircella, Elena, Gaia Casalino, Francesco D’Amico, Nicola Pugliese, Michela Maria Dimuccio, Antonio Camarda, and Giancarlo Bozzo. 2022. "In Vitro Antimicrobial Effectiveness Tests Using Garlic (Allium sativum) against Salmonella enterica Subspecies enterica Serovar Enteritidis" Antibiotics 11, no. 11: 1481. https://doi.org/10.3390/antibiotics11111481
APA StyleCircella, E., Casalino, G., D’Amico, F., Pugliese, N., Dimuccio, M. M., Camarda, A., & Bozzo, G. (2022). In Vitro Antimicrobial Effectiveness Tests Using Garlic (Allium sativum) against Salmonella enterica Subspecies enterica Serovar Enteritidis. Antibiotics, 11(11), 1481. https://doi.org/10.3390/antibiotics11111481

